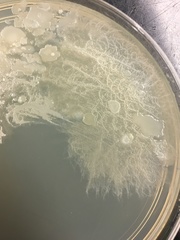
Bacillus
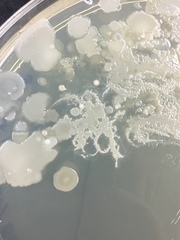
Bacillus
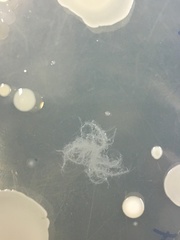
Bacillus
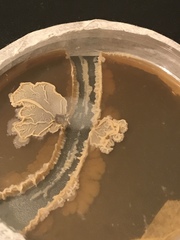
Bacillus

Bacillus: taxon details and analytics
- Domain
- Kingdom
- Bacteria
- Phylum
- Firmicutes
- Class
- Bacilli
- Order
- Bacillales
- Family
- Bacillaceae
- Genus
- Bacillus
- Species
- Scientific Name
- Bacillus
Summary description from Wikipedia:
Bacillus
Bacillus, from Latin "bacillus", meaning "little staff, wand", is a genus of Gram-positive, rod-shaped bacteria, a member of the phylum Bacillota, with 266 named species. The term is also used to describe the shape (rod) of other so-shaped bacteria; and the plural Bacilli is the name of the class of bacteria to which this genus belongs. Bacillus species can be either obligate aerobes which are dependent on oxygen, or facultative anaerobes which can survive in the absence of oxygen. Cultured Bacillus species test positive for the enzyme catalase if oxygen has been used or is present.
Bacillus can reduce themselves to oval endospores and can remain in this dormant state for years. The endospore of one species from Morocco is reported to have survived being heated to 420 °C. Endospore formation is usually triggered by a lack of nutrients: the bacterium divides within its cell wall, and one side then engulfs the other. They are not true spores (i.e., not an offspring). Endospore formation originally defined the genus, but not all such species are closely related, and many species have been moved to other genera of the Bacillota. Only one endospore is formed per cell. The spores are resistant to heat, cold, radiation, desiccation, and disinfectants. Bacillus anthracis needs oxygen to sporulate; this constraint has important consequences for epidemiology and control. In vivo, B. anthracis produces a polypeptide (polyglutamic acid) capsule that kills it from phagocytosis. The genera Bacillus and Clostridium constitute the family Bacillaceae. Species are identified by using morphologic and biochemical criteria. Because the spores of many Bacillus species are resistant to heat, radiation, disinfectants, and desiccation, they are difficult to eliminate from medical and pharmaceutical materials and are a frequent cause of contamination. Not only are they resistant to heat, radiation, etc., but they are also resistant to chemicals such as antibiotics. This resistance allows them to survive for many years and especially in a controlled environment. Bacillus species are well known in the food industries as troublesome spoilage organisms.
Ubiquitous in nature, Bacillus includes symbiotic (sometimes referred to as endophytes) as well as independent species. Two species are medically significant: B. anthracis causes anthrax; and B. cereus causes food poisoning.
Many species of Bacillus can produce copious amounts of enzymes, which are used in various industries, such as in the production of alpha amylase used in starch hydrolysis and the protease subtilisin used in detergents. B. subtilis is a valuable model for bacterial research. Some Bacillus species can synthesize and secrete lipopeptides, in particular surfactins and mycosubtilins. Bacillus species are also found in marine sponges. Marine sponge associated Bacillus subtilis (strains WS1A and YBS29) can synthesize several antimicrobial peptides. These Bacillus subtilis strains can develop disease resistance in Labeo rohita.
...Images from inaturalist.org observations:
We recommend you sign up for this excellent, free service.
Parent Taxon
Sibling Taxa
Child Taxa
- Bacillus amyloliquefaciens
- Bacillus anthracis
- Bacillus cereus
- Bacillus circulans
- Bacillus coahuilensis
- Bacillus djibelorensis
- Bacillus fumarioli
- Bacillus fusiformis
- Bacillus granadensis
- Bacillus hwajinpoensis
- Bacillus insolitus
- Bacillus licheniformis
- Bacillus longiquaesitum
- Bacillus megaterium
- Bacillus muralis
- Bacillus mycoides
- Bacillus niameyensis
- Bacillus odysseyi
- Bacillus ohbensis
- Bacillus olivae
- Bacillus paralicheniformis
- Bacillus pseudomegaterium
- Bacillus psychrodurans
- Bacillus psychrotolerans
- Bacillus pumilus
- Bacillus simplex
- Bacillus sphaericus
- Bacillus subtilis
- Bacillus thermoamyloliquefaciens
- Bacillus thuringiensis